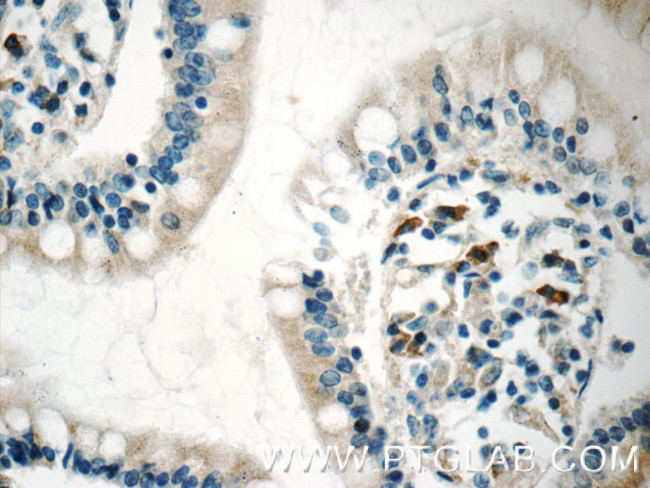
CD244 Antibody in Immunohistochemistry (Paraffin) (IHC (P))

Search
Proteintech
CD244 Polyclonal Antibody
{{$productOrderCtrl.translations['antibody.pdp.commerceCard.promotion.promotions']}}
{{$productOrderCtrl.translations['antibody.pdp.commerceCard.promotion.viewpromo']}}
{{$productOrderCtrl.translations['antibody.pdp.commerceCard.promotion.promocode']}}: {{promo.promoCode}} {{promo.promoTitle}} {{promo.promoDescription}}. {{$productOrderCtrl.translations['antibody.pdp.commerceCard.promotion.learnmore']}}
产品信息
16677-1-AP
种属反应
宿主/亚型
分类
类型
抗原
偶联物
形式
浓度
规格
纯化类型
保存液
内含物
保存条件
运输条件
产品详细信息
Immunogen sequence: GCQGSADHV VSISGVPLQL QPNSIQTKVD SIAWKKLLPS QNGFHHILKW ENGSLPSNTS NDRFSFIVKN LSLLIKAAQQ QDSGLYCLEV TSISGKVQTA TFQVFVFDKV EKPRLQGQGK ILDRGRCQVA LSCLVSRDGN VSYAWYRGSK LIQTAGNLTY LDEEVDINGT HTYTCNVSNP VSWESHTLNL TQDCQNAHQE F (21-220 aa encoded by BC053985)
靶标信息
CD244 (2B4, SLAMF4) is a cell surface receptor expressed on natural killer (NK) cells (and some T cells) that mediate non-major histocompatibility complex (MHC) restricted killing. The interaction between NK-cell and target cells via CD244 is thought to modulate NK-cell cytolytic activity. CD244 interacts with SLAMF2, causing the activation of both SLAMF4- and SLAMF2-expressing cells. Patients with systemic lupus erythmatosus have lower than normal levels of SLAMF4 expressed on their NK cells and monocytes, suggesting that SLAMF4 may play a role in the pathology of this autoimmune disease. Diseases associated with CD244 dysfunction include rheumatoid arthritis and lymphoproliferative syndrome. Alternatively spliced transcript variants encoding different isoforms of CD244 have been found for this gene.
仅用于科研。不用于诊断过程。未经明确授权不得转售。
生物信息学
蛋白别名: alternatively spliced; CD244; CD244 molecule, natural killer cell receptor 2B4; cell surface glycoprotein; immunoglobulin superfamily; h2B4; NAIL; Natural killer cell receptor 2B4; NK cell activation inducing ligand NAIL; NK cell activation-inducing ligand; NK cell type I receptor protein 2B4; NKR Nmrk; NKR2B4; Signaling lymphocytic activation molecule 4; SLAM family member 4; SLAMF4; unnamed protein product
基因别名: 2B4; CD244; NAIL; NKR2B4; Nmrk; SLAMF4
UniProt ID: (Human) Q9BZW8
Entrez Gene ID: (Human) 51744